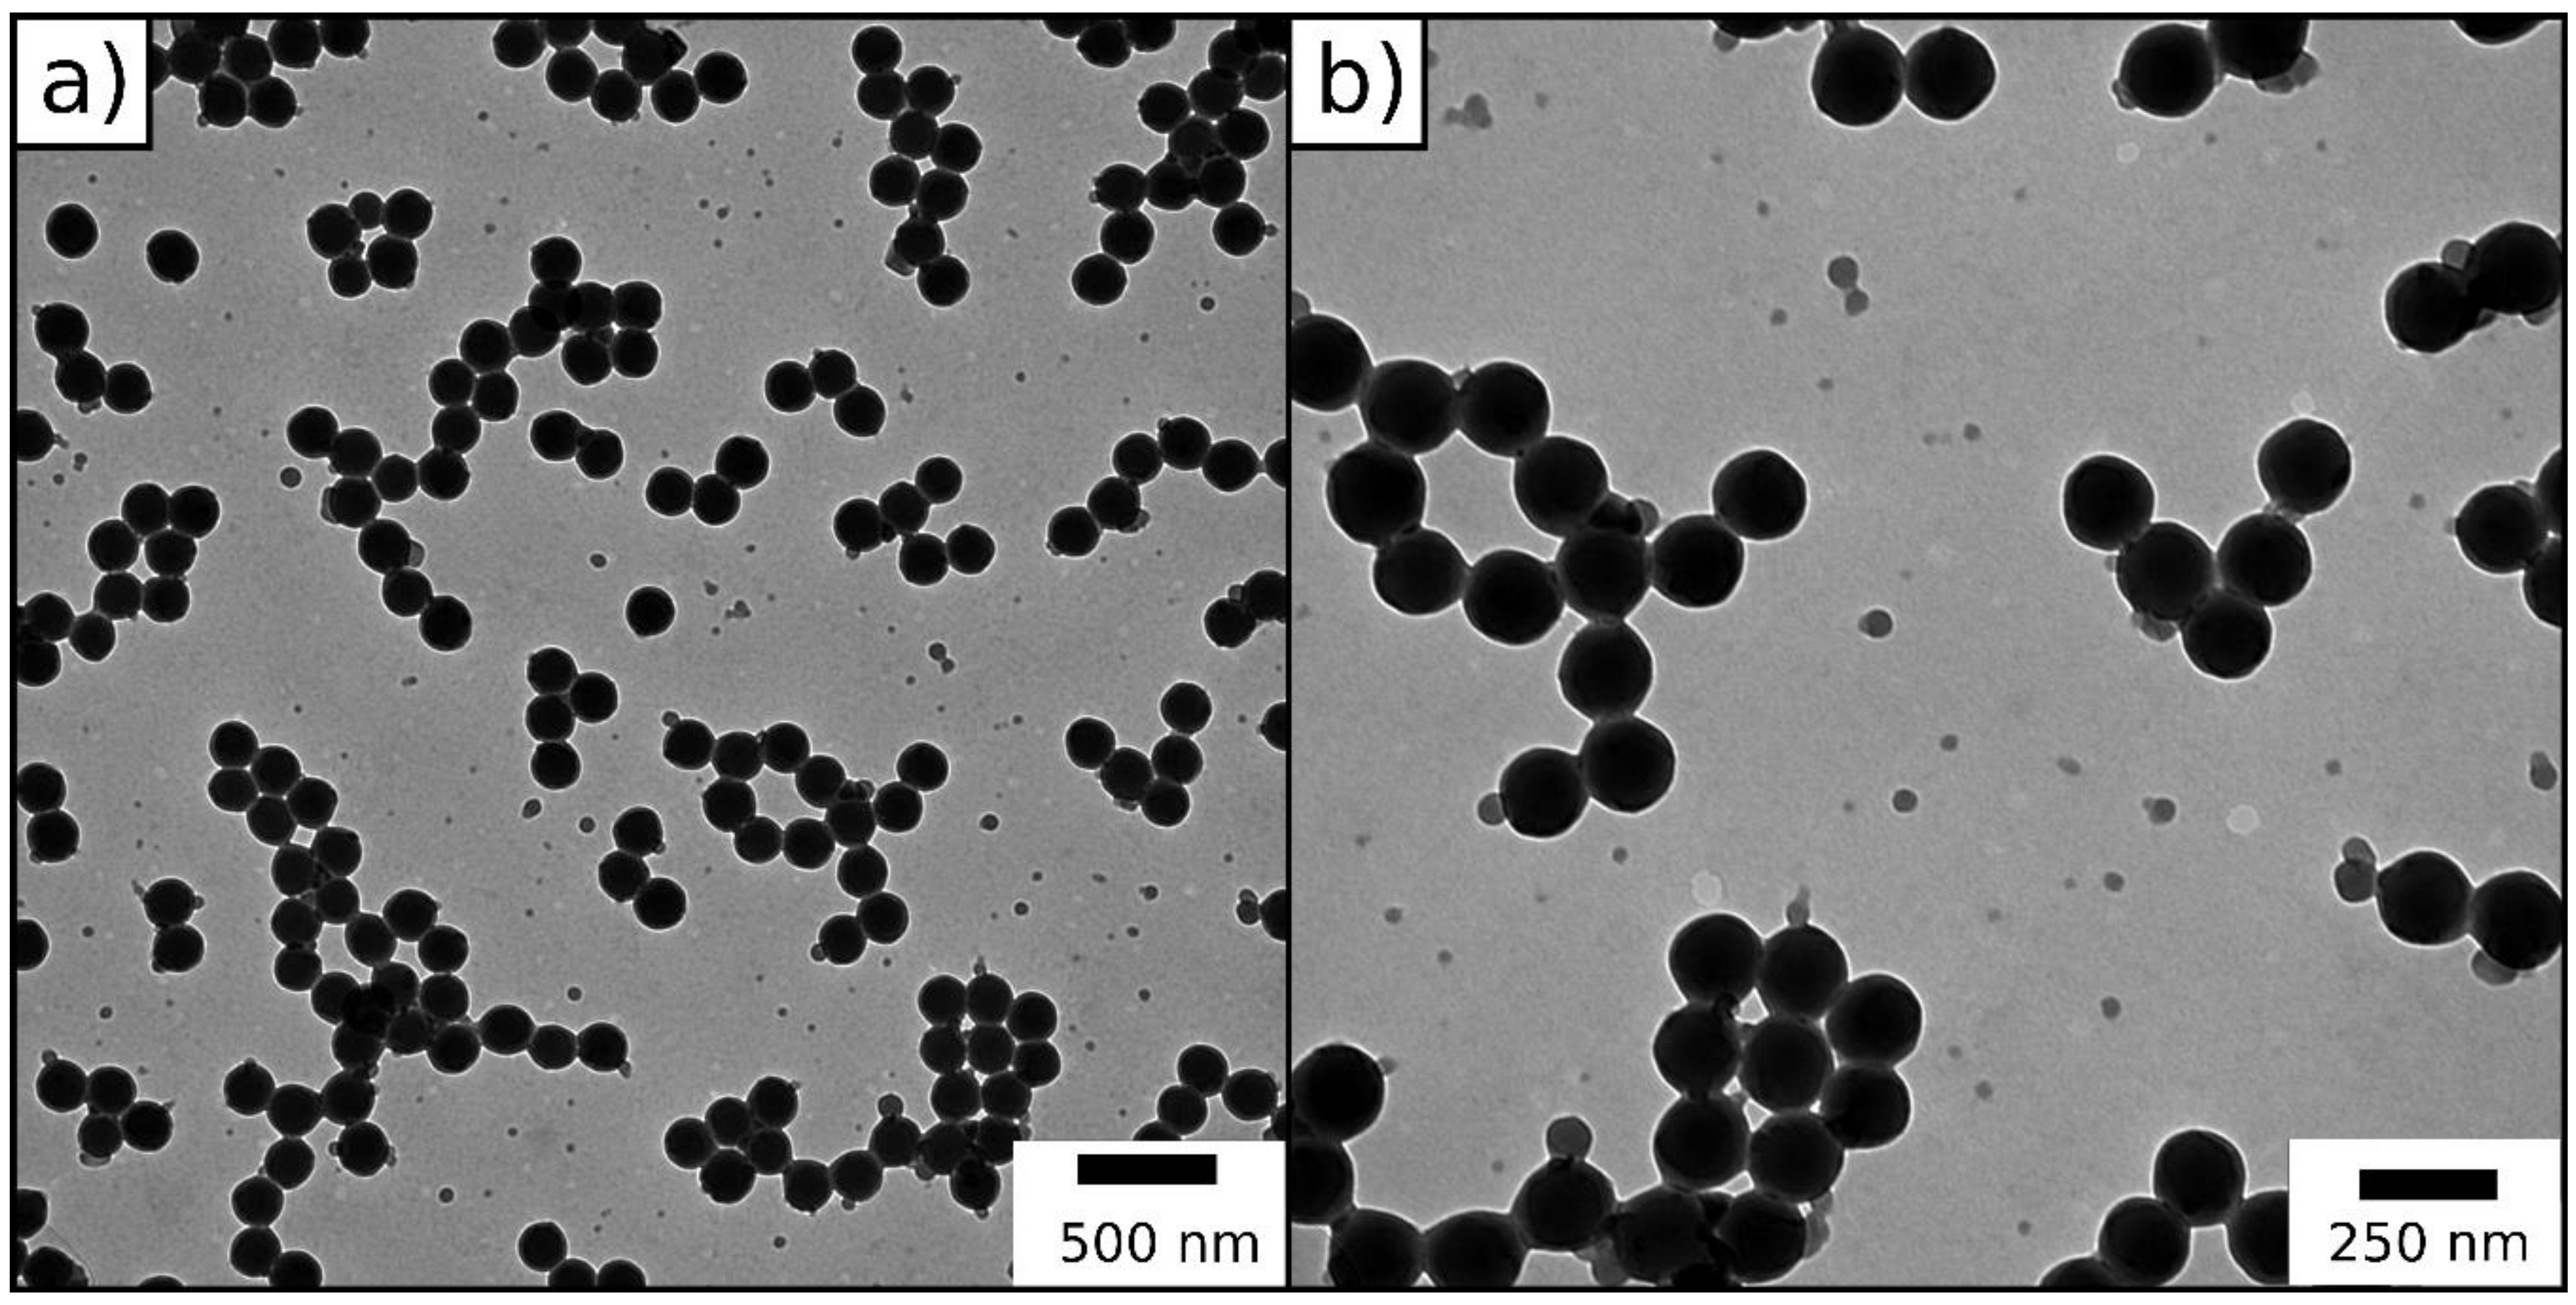
Molecules 24 03553 g008

Combining Soft Polysilazanes with Melt-Shear Organization of Core–Shell Particles: On the Road to Polymer-Templated Porous Ceramics
Abstract
1. Introduction
2. Results and Discussion
2.1. Preparation of Porous SiCN -Ceramics via Free Radical Polymerization (FRP)
2.1.1. Particle Synthesis via Starved-Feed Emulsion Polymerization
2.1.2. Free Radical Polymerization of Durazane1800 on P(MMA-co-ALMA) Particles
2.2. Preparation of Porous SiCN Ceramics via ATRP
2.2.1. ATRP Inimer Particle Synthesis via Starved-Feed Emulsion Polymerization
2.2.2. Grafting from ATRP of Durazane1800 on the Surface of BBEM-Containing Particles
3. Materials and Methods
3.1. Synthesis of P(MMA-co-ALMA) Particles for FRP
3.2. Synthesis of P(MMA-co-ALMA)@P(ALMA-co-BBEM) for ATRP
3.3. Functionalization with Durazane1800 Using FRP
3.4. Functionalization with Durazane1800 Using ATRP
3.5. Melt-Shear Organization
3.6. Characterization
4. Conclusions
Supplementary Materials
Author Contributions
Funding
Acknowledgments
Conflicts of Interest
References
- Colombo, P.; Mera, G.; Riedel, R.; Soraru, G.D. Polymer-derived ceramics: 40 years of research and innovation in advanced ceramics. J. Am. Ceram. Soc. 2010, 93, 1805–1837. [Google Scholar] [CrossRef]
- Mera, G.; Gallei, M.; Bernard, S.; Ionescu, E. Ceramic Nanocomposites from Tailor-Made Preceramic Polymers. Nanomaterials-Basel 2015, 5, 468–540. [Google Scholar] [CrossRef] [PubMed]
- Mera, G.; Navrotsky, A.; Sen, S.; Kleebe, H.-J.; Riedel, R. Polymer-derived SiCN and SiOC ceramics–structure and energetics at the nanoscale. J. Mater. Chem. A 2013, 1, 3826–3836. [Google Scholar] [CrossRef]
- Riedel, R.; Mera, G.; Hauser, R.; Klonczynski, A. Silicon-based polymer-derived ceramics: Synthesis properties and applications-a review dedicated to Prof. Dr. Fritz Aldinger on the occasion of his 65th birthday. J. Ceram. Soc. Jpn. 2006, 114, 425–444. [Google Scholar] [CrossRef]
- Ionescu, E.; Bernard, S.; Lucas, R.; Kroll, P.; Ushakov, S.; Navrotsky, A.; Riedel, R. Polymer-Derived Ultra-High Temperature Ceramics (UHTCs) and Related Materials. Adv. Eng. Mater. 2019, 21. [Google Scholar] [CrossRef]
- Ionescu, E.; Kleebe, H.J.; Riedel, R. Silicon-containing polymer-derived ceramic nanocomposites (PDC-NCs): Preparative approaches and properties. Chem. Soc. Rev. 2012, 41, 5032–5052. [Google Scholar] [CrossRef] [PubMed]
- Stabler, C.; Ionescu, E.; Graczyk-Zajac, M.; Gonzalo-Juan, I.; Riedel, R. Silicon oxycarbide glasses and glass-ceramics: “All-Rounder” materials for advanced structural and functional applications. J. Am. Ceram. Soc. 2018, 101, 4817–4856. [Google Scholar] [CrossRef]
- Weinmann, M.; Ionescu, E.; Riedel, R.; Aldinger, F. Precursor-Derived Ceramics. Handb. Adv. Ceram. Mater. Appl. Process. Prop. 2nd Ed. 2013, 1025–1101. [Google Scholar] [CrossRef]
- Lale, A.; Schmidt, M.; Mallmann, M.D.; Bezerra, A.V.A.; Acosta, E.D.; Machado, R.A.F.; Demirci, U.B.; Bernard, S. Polymer-Derived Ceramics with engineered mesoporosity: From design to application in catalysis. Surf. Coat. Tech. 2018, 350, 569–586. [Google Scholar] [CrossRef]
- Bernard, S.; Miele, P. Ordered mesoporous polymer-derived ceramics and their processing into hierarchically porous boron nitride and silicoboron carbonitride monoliths. New J. Chem. 2014, 38, 1923–1931. [Google Scholar] [CrossRef]
- Bernard, S.; Miele, P. Polymer-derived ordered mesoporous silicon-boron-carbon-nitrogen (Si/B/C/N) ceramics. J. Ceram. Sci. Technol. 2013, 4, 113–122. [Google Scholar] [CrossRef]
- Lu, K. Porous and high surface area silicon oxycarbide-based materials—a review. Mater. Sci. Eng. R Rep. 2015, 97, 23–49. [Google Scholar] [CrossRef]
- Vakifahmetoglu, C.; Zeydanli, D.; Colombo, P. Porous polymer derived ceramics. Mater. Sci. Eng. R Rep. 2016, 106, 1–30. [Google Scholar] [CrossRef]
- Vakifahmetoglu, C.; Zeydanli, D.; Ozalp, V.C.; Borsa, B.A.; Soraru, G.D. Hierarchically porous polymer derived ceramics: A promising platform for multidrug delivery systems. Mater. Des. 2018, 140, 37–44. [Google Scholar] [CrossRef]
- Schumacher, D.; Wilhelm, M.; Rezwan, K. Modified solution based freeze casting process of polysiloxanes to adjust pore morphology and surface functions of SiOC monoliths. Mater. Des. 2018, 160, 1295–1304. [Google Scholar] [CrossRef]
- Zhang, H.; Nunes, P.D.A.; Wilhelm, M.; Rezwan, K. Hierarchically ordered micro/meso/macroporous polymer-derived ceramic monoliths fabricated by freeze-casting. J. Eur. Ceram. Soc. 2016, 36, 51–58. [Google Scholar] [CrossRef]
- Prenzel, T.; Wilhelm, M.; Rezwan, K. Pyrolyzed polysiloxane membranes with tailorable hydrophobicity, porosity and high specific surface area. Microporous Mesoporous Mater. 2013, 169, 160–167. [Google Scholar] [CrossRef]
- Jüttke, Y.; Richtera, H.; Voigta, I.; Prasadb, R.M.; Bazarjanib, M.S.; Gurlob, A.; Riedelb, R. Polymer derived ceramic membranes for gas separation. Chem. Eng. 2013, 32. [Google Scholar] [CrossRef]
- Konegger, T.; Tsai, C.-C.; Peterlik, H.; Creager, S.E.; Bordia, R.K. Asymmetric polysilazane-derived ceramic structures with multiscalar porosity for membrane applications. Microporous Mesoporous Mater. 2016, 232, 196–204. [Google Scholar] [CrossRef]
- Konegger, T.; Williams, L.F.; Bordia, R.K. Planar, polysilazane-derived porous ceramic supports for membrane and catalysis applications. J. Am. Ceram. Soc. 2015, 98, 3047–3053. [Google Scholar] [CrossRef]
- Colombo, P. Engineering porosity in polymer-derived ceramics. J. Eur. Ceram. Soc. 2008, 28, 1389–1395. [Google Scholar] [CrossRef]
- Sung, I.-K.; Mitchell, C.M.; Kim, D.-P.; Kenis, P.J.A. Tailored Macroporous SiCN and SiC Structures for High-Temperature Fuel Reforming. Adv. Funct. Mater. 2005, 15, 1336–1342. [Google Scholar] [CrossRef]
- Wang, H.; Zheng, S.-y.; Li, X.-d.; Kim, D.-p. Preparation of three-dimensional ordered macroporous SiCN ceramic using sacrificing template method. Microporous Mesoporous Mater. 2005, 80, 357–362. [Google Scholar] [CrossRef]
- Xiao, Z.; Wang, A.; Kim, D.-P. 3D macroporous SiCN ceramic patterns tailored by thermally-induced deformation of template. J. Mater. Chem. 2010, 20, 2853–2857. [Google Scholar] [CrossRef]
- Colombo, P. Conventional and novel processing methods for cellular ceramics. Phil. Trans. Math. Phys. Eng. Sci. 2006, 364, 109–124. [Google Scholar] [CrossRef] [PubMed]
- Studart, A.R.; Gonzenbach, U.T.; Tervoort, E.; Gauckler, L.J. Processing routes to macroporous ceramics: A review. J. Am. Ceram. Soc. 2006, 89, 1771–1789. [Google Scholar] [CrossRef]
- Yoon, T.-H.; Hong, L.-Y.; Kim, D.-P. Fabrication of SiC-based Ceramic Microstructures from Preceramic Polymers with Sacrificial Templates and Softlithography Techniques. In Lithography; Wang, M., Ed.; Intech Open: London, UK, 2010; pp. 427–446. [Google Scholar]
- Colombo, P.; Schmidt, J.; Franchin, G.; Zocca, A.; Gunster, J. Additive manufacturing techniques for fabricating complex ceramic components from preceramic polymers. Am. Ceram. Soc. Bull. 2017, 96, 16–23. [Google Scholar]
- Schmidt, J.; Colombo, P. Digital light processing of ceramic components from polysiloxanes. J. Eur. Ceram. Soc. 2018, 38, 57–66. [Google Scholar] [CrossRef]
- Zocca, A.; Colombo, P.; Gomes, C.M.; Gunster, J. Additive Manufacturing of Ceramics: Issues, Potentialities, and Opportunities. J. Am. Ceram. Soc. 2015, 98, 1983–2001. [Google Scholar] [CrossRef]
- Eckel, Z.C.; Zhou, C.Y.; Martin, J.H.; Jacobsen, A.J.; Carter, W.B.; Schaedler, T.A. 3D PRINTING Additive manufacturing of polymer-derived ceramics. Science 2016, 351, 58–62. [Google Scholar] [CrossRef]
- Naviroj, M.; Miller, S.M.; Colombo, P.; Faber, K.T. Directionally aligned macroporous SiOC via freeze casting of preceramic polymers. J. Eur. Ceram. Soc. 2015, 35, 2225–2232. [Google Scholar] [CrossRef]
- Grebenyuk, Y.; Zhang, H.X.; Wilhelm, M.; Rezwan, K.; Dreyer, M.E. Wicking into porous polymer-derived ceramic monoliths fabricated by freeze-casting. J. Eur. Ceram. Soc. 2017, 37, 1993–2000. [Google Scholar] [CrossRef]
- Zhang, Z.; Shen, W.; Ye, C.; Luo, Y.; Li, S.; Li, M.; Xu, C.; Song, Y. Large-area, crack-free polysilazane-based photonic crystals. J. Mater. Chem. 2012, 22, 5300–5303. [Google Scholar] [CrossRef]
- Ewert, J.-K.; Denner, C.; Friedrich, M.; Motz, G.; Kempe, R. Meso-Structuring of SiCN Ceramics by Polystyrene Templates. Nanomaterials-Basel 2015, 5, 425–435. [Google Scholar] [CrossRef] [PubMed]
- Colombo, P.; Bernardo, E.; Biasetto, L. Novel Microcellular Ceramics from a Silicone Resin. J. Am. Ceram. Soc. 2004, 87, 152–154. [Google Scholar] [CrossRef]
- Kim, Y.-W.; Kim, S.-H.; Kim, H.-D.; Park, C.B. Processing of closed-cell silicon oxycarbide foams from a preceramic polymer. J. Mater. Sci. 2004, 39, 5647–5652. [Google Scholar] [CrossRef]
- Vakifahmetoglu, C.; Menapace, I.; Hirsch, A.; Biasetto, L.; Hauser, R.; Riedel, R.; Colombo, P. Highly porous macro- and micro-cellular ceramics from a polysilazane precursor. Ceram. Int. 2009, 35, 3281–3290. [Google Scholar] [CrossRef]
- Wang, C.M.; Wang, J.; Park, C.B.; Kim, Y.W. Processing of porous silicon oxycarbide ceramics from extruded blends of polysiloxane and low-density polyethylene. J. Ceram. Process. Res. 2009, 10, 238–242. [Google Scholar] [CrossRef]
- Schmalz, T.; Hausherr, J.M.; Mueller, W.; Kraus, T.; Krenkel, W.; Kempe, R.; Motz, G. Analysis of polyethylene-particle filled SiCN precursor and the resulting porous ceramics with emphasis on using micro computed tomography. J. Ceram. Soc. Jpn. 2011, 119, 477–482. [Google Scholar] [CrossRef][Green Version]
- Nedunchezhian, S.; Sujith, R.; Kumar, R. Processing and characterization of polymer precursor derived silicon oxycarbide ceramic foams and compacts. J. Adv. Ceram. 2013, 2, 318–324. [Google Scholar] [CrossRef][Green Version]
- Kaur, S.; Gallei, M.; Ionescu, E. Polymer–Ceramic Nanohybrid Materials. Adv. Polym. Sci. 2015, 267, 143–185. [Google Scholar] [CrossRef]
- Schäfer, C.G.; Vowinkel, S.; Hellmann, G.P.; Herdt, T.; Contiu, C.; Schneider, J.J.; Gallei, M. A polymer based and template-directed approach towards functional multidimensional microstructured organic/inorganic hybrid materials. J. Mater. Chem. C. 2014, 2, 7960–7975. [Google Scholar] [CrossRef]
- Winter, T.; Su, X.; Hatton, T.A.; Gallei, M. Ferrocene-Containing Inverse Opals by Melt-Shear Organization of Core/Shell Particles. Macromol. Rapid Commun. 2018, 1800428. [Google Scholar] [CrossRef]
- Schäfer, C.G.; Winter, T.; Heidt, S.; Dietz, C.; Ding, T.; Baumberg, J.J.; Gallei, M. Smart polymer inverse-opal photonic crystal films by melt-shear organization for hybrid core–shell architectures. J. Mater. Chem. C. 2015, 3, 2204–2214. [Google Scholar] [CrossRef]
- Vowinkel, S.; Schäfer, C.G.; Cherkashinin, G.; Fasel, C.; Roth, F.; Liu, N.; Dietz, C.; Ionescu, E.; Gallei, M. 3D-ordered carbon materials by melt-shear organization for tailor-made hybrid core–shell polymer particle architectures. J. Mater. Chem. C. 2016, 4, 3976–3986. [Google Scholar] [CrossRef]
- Vowinkel, S.; Malz, F.; Rode, K.; Gallei, M. Single-source macroporous hybrid materials by melt-shear organization of core–shell particles. J. Mater. Sci. 2017, 52, 11179–11190. [Google Scholar] [CrossRef]
- Vowinkel, S.; Boehm, A.; Schäfer, T.; Gutmann, T.; Ionescu, E.; Gallei, M. Preceramic Core-Shell Particles for the Preparation of Hybrid Colloidal Crystal Films by Melt-Shear Organization and Conversion into Porous Ceramics. Mater. Des. 2018, 160, 926–935. [Google Scholar] [CrossRef]
- Gallei, M. Functional Polymer Opals and Porous Materials by Shear-Induced Assembly of Tailor-Made Particles. Macromol. Rapid Commun. 2018, 39, 1700648. [Google Scholar] [CrossRef]
- Wang, K.; Wen, H.-F.; Yu, D.-G.; Yang, Y.; Zhang, D.-F. Electrosprayed hydrophilic nanocomposites coated with shellac for colon-specific delayed drug delivery. Mater. Des. 2018, 143, 248–255. [Google Scholar] [CrossRef]
- Yu, D.-G.; Zheng, X.-L.; Yang, Y.; Li, X.-Y.; Williams, G.R.; Zhao, M. Immediate release of helicid from nanoparticles produced by modified coaxial electrospraying. Appl. Surf. Sci. 2019, 473, 148–155. [Google Scholar] [CrossRef]
- Yang, Y.-Y.; Zhang, M.; Wang, K.; Yu, D.-G. pH-sensitive polymer nanocoating on hydrophilic composites fabricated using modified coaxial electrospraying. Mater. Lett. 2018, 227, 93–96. [Google Scholar] [CrossRef]
- Duda, Y.; Vázquez, F. Modeling of composite latex particle morphology by off-lattice Monte Carlo simulation. Langmuir 2005, 21, 1096–1102. [Google Scholar] [CrossRef] [PubMed]
- Kroke, E.; Li, Y.-L.; Konetschny, C.; Lecomte, E.; Fasel, C.; Riedel, R. Silazane derived ceramics and related materials. Mater. Sci. Eng. R Rep. 2000, 26, 97–199. [Google Scholar] [CrossRef]
- Flores, O.; Schmalz, T.; Krenkel, W.; Heymann, L.; Motz, G. Selective cross-linking of oligosilazanes to tailored meltable polysilazanes for the processing of ceramic SiCN fibres. J. Mater. Chem. A 2013, 1, 15406–15415. [Google Scholar] [CrossRef]
- Furtat, P.; Lenz-Leite, M.; Ionescu, E.; Machado, R.A.F.; Motz, G. Synthesis of fluorine-modified polysilazanes via Si–H bond activation and their application as protective hydrophobic coatings. J. Mater. Chem. A. 2017, 5, 25509–25521. [Google Scholar] [CrossRef]
- Viel, B.; Ruhl, T.; Hellmann, G.P. Reversible Deformation of Opal Elastomers. Chem. Mater. 2007, 19, 5673–5679. [Google Scholar] [CrossRef]
- Schäfer, C.G.; Viel, B.; Hellmann, G.P.; Rehahn, M.; Gallei, M. Thermo-cross-linked Elastomeric Opal Films. ACS Appl. Mater. Interfaces 2013, 5, 10623–10632. [Google Scholar] [CrossRef]
- Schäfer, C.G.; Gallei, M.; Zahn, J.T.; Engelhardt, J.; Hellmann, G.P.; Rehahn, M. Reversible Light-, Thermo-, and Mechano-Responsive Elastomeric Polymer Opal Films. Chem. Mater. 2013, 25, 2309–2318. [Google Scholar] [CrossRef]
- Scheid, D.; Lederle, C.; Vowinkel, S.; Schäfer, C.G.; Stühn, B.; Gallei, M. Redox- and mechano-chromic response of metallopolymer-based elastomeric colloidal crystal films. J. Mater. Chem. C 2014, 2, 2583–2590. [Google Scholar] [CrossRef]
- Ruhl, T.; Hellmann, G.P. Colloidal Crystals in Latex Films: Rubbery Opals. Macromol. Chem. Phys. 2001, 202, 3502–3505. [Google Scholar] [CrossRef]
- Ruhl, T.; Spahn, P.; Hellmann, G.P. Artificial opals prepared by melt compression. Polymer 2003, 44, 7625–7634. [Google Scholar] [CrossRef]
- Schäfer, C.G.; Lederle, C.; Zentel, K.; Stuhn, B.; Gallei, M. Utilizing stretch-tunable thermochromic elastomeric opal films as novel reversible switchable photonic materials. Macromol. Rapid Commun. 2014, 35, 1852–1860. [Google Scholar] [CrossRef] [PubMed]
- Kojima, A.; Hoshii, S.; Muto, T. Characteristics of polysilazane compound and its application as coating for carbon material. J. Mater. Sci. Lett. 2002, 21, 757–760. [Google Scholar] [CrossRef]
- Konegger, T.; Patidar, R.; Bordia, R.K. A novel processing approach for free-standing porous non-oxide ceramic supports from polycarbosilane and polysilazane precursors. J. Eur. Ceram. Soc. 2015, 35, 2679–2683. [Google Scholar] [CrossRef] [PubMed]
- D’Elia, R.; Dusserre, G.; Del Confetto, S.; Eberling-Fux, N.; Descamps, C.; Cutard, T. Cure kinetics of a polysilazane system: Experimental characterization and numerical modelling. Eur. Polym. J. 2016, 76, 40–52. [Google Scholar] [CrossRef]
- Ferriol, M.; Gentilhomme, A.; Cochez, M.; Oget, N.; Mieloszynski, J. Thermal degradation of poly (methyl methacrylate)(PMMA): Modelling of DTG and TG curves. Polm. Degrad. Stabil. 2003, 79, 271–281. [Google Scholar] [CrossRef]
- Zoppe, J.O.; Ataman, N.C.; Mocny, P.; Wang, J.; Moraes, J.; Klok, H.A. Surface-Initiated Controlled Radical Polymerization: State-of-the-Art, Opportunities, and Challenges in Surface and Interface Engineering with Polymer Brushes. Chem. Rev. 2017, 117, 1105–1318. [Google Scholar] [CrossRef]
- Mazurowski, M.; Gallei, M.; Li, J.; Didzoleit, H.; Stühn, B.; Rehahn, M. Redox-Responsive Polymer Brushes Grafted from Polystyrene Nanoparticles by Means of Surface Initiated Atom Transfer Radical Polymerization. Macromolecules 2012, 45, 8970–8981. [Google Scholar] [CrossRef]
- Matyjaszewski, K. Atom Transfer Radical Polymerization (ATRP): Current Status and Future Perspectives. Macromolecules 2012, 45, 4015–4039. [Google Scholar] [CrossRef]
Sample Availability: Samples of the compounds (particles, colloidal crystals, porous ceramics) are available from the authors. |

| Method | Diameter (nm) | Ð |
|---|---|---|
| DLS | 147.8 ± 2.1 | 0.042 |
| TEM | 128.9 ± 1.6 | - |
| Method | Diameter (nm) | Ð |
|---|---|---|
| DLS | 201.2 ± 4.4 | 0.008 |
| TEM | 183.7 ± 6.7 | - |
© 2019 by the authors. Licensee MDPI, Basel, Switzerland. This article is an open access article distributed under the terms and conditions of the Creative Commons Attribution (CC BY) license (http://creativecommons.org/licenses/by/4.0/).
Share and Cite
Boehm, A.K.; Ionescu, E.; Koch, M.; Gallei, M. Combining Soft Polysilazanes with Melt-Shear Organization of Core–Shell Particles: On the Road to Polymer-Templated Porous Ceramics. Molecules 2019, 24, 3553. https://doi.org/10.3390/molecules24193553
Boehm AK, Ionescu E, Koch M, Gallei M. Combining Soft Polysilazanes with Melt-Shear Organization of Core–Shell Particles: On the Road to Polymer-Templated Porous Ceramics. Molecules. 2019; 24(19):3553. https://doi.org/10.3390/molecules24193553
Chicago/Turabian StyleBoehm, Anna K., Emanuel Ionescu, Marcus Koch, and Markus Gallei. 2019. "Combining Soft Polysilazanes with Melt-Shear Organization of Core–Shell Particles: On the Road to Polymer-Templated Porous Ceramics" Molecules 24, no. 19: 3553. https://doi.org/10.3390/molecules24193553
APA StyleBoehm, A. K., Ionescu, E., Koch, M., & Gallei, M. (2019). Combining Soft Polysilazanes with Melt-Shear Organization of Core–Shell Particles: On the Road to Polymer-Templated Porous Ceramics. Molecules, 24(19), 3553. https://doi.org/10.3390/molecules24193553

